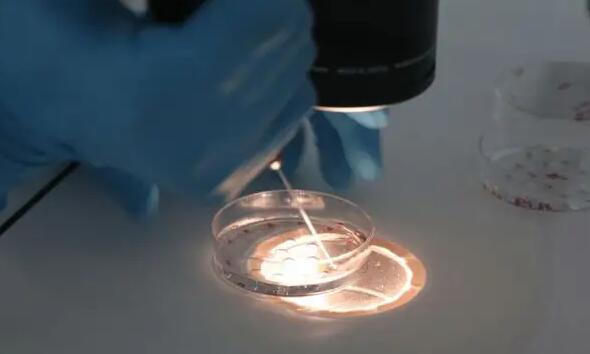
廣州哪家試管醫(yī)院好 在廣州試管嬰兒費(fèi)用是多少?在廣州,試管嬰兒的條件是什么? ‘孕囊4.2×1.6是男是女’

廣州哪家試管醫(yī)院好 在廣州試管嬰兒費(fèi)用是多少?在廣州,試管嬰兒的條件是什
廣州哪家試管醫(yī)院好
選擇助孕機(jī)構(gòu),首先要查看它是否擁有相關(guān)資質(zhì)。正規(guī)的助孕機(jī)構(gòu)應(yīng)該具備醫(yī)療機(jī)構(gòu)執(zhí)業(yè)許可證或民政部門頒發(fā)的合法助孕機(jī)構(gòu)證書。此外,還可以查看它是否有醫(yī)療保險(xiǎn)資質(zhì)、是否符合相關(guān)法規(guī)、是否有良好的信譽(yù)等。

廣州市生殖科前五醫(yī)院排名情況表
第1名:
廣醫(yī)附三:廣醫(yī)三院生殖醫(yī)學(xué)中心是廣東省規(guī)模最大、成功率最高的生殖中心之一,對(duì)不孕不育的診治有著悠久的歷史,是全國(guó)最早開(kāi)展輔助生殖技術(shù)的醫(yī)療機(jī)構(gòu)之一。1989年,誕生了廣東省第一、第二例試管嬰兒,成為全國(guó)第三家取得成功的單位,標(biāo)志著廣東乃至整個(gè)華南地區(qū)的生殖技術(shù)取得革命性突破。至今輔助生殖超6.5萬(wàn)周期,2019年中心門診接待病人量約30萬(wàn)人次,妊娠率超55%。
第二名:
廣東婦幼:成立于2000年,是早期獲得衛(wèi)生部人類輔助生殖技術(shù)準(zhǔn)入的生殖中心之一。每年進(jìn)行8千多各類輔助生殖技術(shù)治療周期,已誕生2萬(wàn)3千多試管寶寶。第三代“試管嬰兒”PGD臨床妊娠率高達(dá)68%,PGS臨床妊娠率為62%,居國(guó)內(nèi)外領(lǐng)先水平。卵子冷凍技術(shù)成熟,現(xiàn)冷凍卵子復(fù)蘇移植周期臨床妊娠率高達(dá)60%,屬國(guó)內(nèi)一流水平。費(fèi)用大概是在5-8萬(wàn)
第三名:
廣中一附屬:生殖醫(yī)學(xué)中心創(chuàng)建于1989年,生殖醫(yī)學(xué)專科人員具有扎實(shí)的婦科生殖內(nèi)分泌基礎(chǔ)、成熟的超排卵監(jiān)測(cè)技術(shù),以及常規(guī)體外受精-胚胎移植技術(shù)、細(xì)胞培養(yǎng)技術(shù)、單精子卵胞質(zhì)內(nèi)顯微注射技術(shù)、胚胎活檢技術(shù)和分子生物學(xué)診斷技術(shù)等,胚胎移植4000余周期,總體妊娠率穩(wěn)定在45%左右,冷凍胚胎移植2000余周期,總體妊娠率達(dá)40%以上。費(fèi)用:4-8萬(wàn)元此外,還進(jìn)行人工授精1300多周期,周期成功率達(dá)13%左右
第四名:
孫逸仙紀(jì)念醫(yī)院:試管嬰兒成功率:40%-55%;試管嬰兒費(fèi)用:3-6萬(wàn)元,中山醫(yī)科大學(xué)孫逸仙紀(jì)念醫(yī)院成立于1835年,在1970年就在國(guó)內(nèi)較早開(kāi)展了人工授精輔助生育技術(shù),2001年建立了生殖中心,全面開(kāi)展現(xiàn)代輔助生育技術(shù),按照不孕不育診治規(guī)范不孕不育患者,并設(shè)有生殖醫(yī)學(xué)中心和宮腔鏡室,是目前廣東省較大的生殖醫(yī)學(xué)中心之一。
第五名:
廣州婦女兒童醫(yī)院:成功率穩(wěn)定在55%,試管嬰兒費(fèi)用4-7萬(wàn)廣州市婦女兒童醫(yī)療中心生殖醫(yī)學(xué)中心目前可進(jìn)行誘發(fā)排卵排卵監(jiān)測(cè)、夫精人工受精,體外受精胚胎移植、卵胞漿內(nèi)單精子注射,胚胎植入前遺傳學(xué)診斷等各項(xiàng)輔助生殖技術(shù)。廣州市婦女兒童醫(yī)療中心1997年成立生殖健康科,2001年誕生首例試管嬰兒,成功率穩(wěn)定在50%以上,穩(wěn)居全國(guó)先進(jìn)水平。2016年通過(guò)國(guó)家胚胎植入前遺傳學(xué)診斷技術(shù)審查,成為國(guó)內(nèi)少數(shù)幾家擁有胚胎植入前遺傳學(xué)診斷技術(shù)的生殖醫(yī)學(xué)中心之一。
以上就是廣州生殖科技術(shù)較好排名前五的醫(yī)院,分別是廣醫(yī)附三、廣東婦幼、廣東一附屬、孫逸仙紀(jì)念醫(yī)院、廣州婦女兒童醫(yī)院。這些醫(yī)院成功率都非常高,技術(shù)設(shè)備也非常的先進(jìn),可以考慮這五家醫(yī)院進(jìn)行檢查。根據(jù)自己的實(shí)際情況選擇就近治療,同時(shí)也能省下費(fèi)用。希望以上能幫助到大家,謝謝。
廣州買卵子做供卵試管嬰兒的價(jià)格是多少?
廣州給卵試管嬰兒的價(jià)格在6-10萬(wàn)元左右。由于中國(guó)不允許買賣卵子,只需支付治療費(fèi)、營(yíng)養(yǎng)費(fèi)、交通費(fèi)等。在廣州。一般這部分費(fèi)用在3-5萬(wàn)元左右。目前醫(yī)院第一代試管嬰兒平均費(fèi)用在3萬(wàn)元左右,第二代試管嬰兒平均費(fèi)用在5萬(wàn)元左右。如果是給卵試管,需要在此基礎(chǔ)上加3-5萬(wàn)。
廣州供卵試管費(fèi)用
廣州市花都區(qū)婦幼保健院成立于1991年。是一家綜合實(shí)力雄厚的公立二級(jí)甲等婦幼保健院,由政府出資,由遠(yuǎn)游香港的圣人胡忠先生領(lǐng)導(dǎo)。集保健、醫(yī)療、教學(xué)、科研為一體,以產(chǎn)科、婦科、兒科、口腔科、保健為特色。目前,醫(yī)院生殖醫(yī)學(xué)中心已開(kāi)展人工授精、一代試管、二代試管技術(shù)。如果在此基礎(chǔ)上選擇卵子供應(yīng)
一、雙方綜合檢查費(fèi)
夫妻雙方?jīng)Q定,為了保證精子和卵子的質(zhì)量,不孕夫婦應(yīng)進(jìn)行與治療相關(guān)的醫(yī)學(xué)檢查。體檢包括:血型、血常規(guī)、腎功能、乙型肝炎丙型肝炎檢查、精液培養(yǎng)、陰道分泌物培養(yǎng)、艾滋病篩查、宮頸癌檢查等。這部分費(fèi)用約為2000-4000元。
二、供卵費(fèi)用
根據(jù)國(guó)家規(guī)定,供卵者還必須符合試管嬰兒輔助妊娠治療的醫(yī)學(xué)指標(biāo),在促排卵周期內(nèi)一次至少獲得20個(gè)成熟卵子can-dont卵子,卵子供應(yīng)商必須保留至少15個(gè),其余的必須捐贈(zèng)給他人。一般免費(fèi),只需支付卵子治療費(fèi)、營(yíng)養(yǎng)費(fèi)、交通費(fèi)等。
第三,手術(shù)費(fèi)用
手術(shù)費(fèi)用包括取卵、實(shí)驗(yàn)室胚胎培養(yǎng)(包括精卵體外治療、體外受精、體外胚胎培養(yǎng))、胚胎染色體基因篩查、胚胎移植等。費(fèi)用在6000-4萬(wàn)元左右。當(dāng)然,這只是一個(gè)循環(huán)。如果試管嬰兒失敗,你將不得不為第二次或第三次移植支付額外費(fèi)用。
做供卵試管需要很長(zhǎng)時(shí)間。
雖然卵子供應(yīng)試管比外國(guó)機(jī)構(gòu)便宜得多,但由于國(guó)家嚴(yán)格的卵子捐獻(xiàn)要求,目前廣州的蛋源緊張,媒體曾經(jīng)出現(xiàn)過(guò)“蛋荒”。等待時(shí)間可能是半年,也可能是3-5年,這很正常。我們還沒(méi)有收集到這家醫(yī)院一些姐妹做卵子試管的費(fèi)用。
在廣州供卵IVF,匹配排卵來(lái)源需要1-2個(gè)月,不超過(guò)4個(gè)月才能進(jìn)入周期。周期治療最早可在3個(gè)月內(nèi)完成,總費(fèi)用約4萬(wàn)元。
巧克力夾心
雞蛋供應(yīng)的成本主要是根據(jù)雞蛋供應(yīng)的外觀、年齡和性格來(lái)估計(jì)的。雞蛋供應(yīng)越年輕,物理質(zhì)量越好,一般賠償越高,具體價(jià)格需要供需雙方商定。
忘記水
常規(guī)試管嬰兒的費(fèi)用一般為3-5萬(wàn)/周期。卵子試管和常規(guī)試管的區(qū)別在于第三方卵子來(lái)源的問(wèn)題,即取卵對(duì)象不同,其他流程相同。卵子試管的一般費(fèi)用在5-10萬(wàn)元之間。
愛(ài)
供卵IVF治療只能在第三方卵子供應(yīng)的幫助下完成。但治療結(jié)果的質(zhì)量并不一定是由女性的單方面因素決定的。收到卵子供應(yīng)的家庭應(yīng)該有這些基本知識(shí)。一般來(lái)說(shuō),廣州卵子供應(yīng)試管的成本約為5萬(wàn)元。如果一個(gè)失敗了,第二個(gè)試管的成本就會(huì)增加。
廣州買卵子做試管嬰兒的價(jià)格是多少?以上是廣州買卵子做試管嬰兒的價(jià)格。全部?jī)?nèi)容。可以咨詢?cè)嚬軏雰横t(yī)院的顧慮,或者想了解更多關(guān)于試管的問(wèn)題,如流程、成本、成功率、多囊調(diào)理、老年試管等。.詢問(wèn)592嬰兒網(wǎng)殖專家解答!
在廣州試管嬰兒費(fèi)用是多少?在廣州,試管嬰兒的條件是什么?
想去廣州做試管的病人,一定要做好體檢,經(jīng)過(guò)醫(yī)生評(píng)估診斷,決定是否適合做試管嬰兒。還有很多種情況下需要做試管嬰兒。
不育:無(wú)論是由炎癥、子宮內(nèi)膜異位癥或結(jié)核引起的輸卵管阻塞,還是先天性的輸卵管缺失,均可進(jìn)行試管。
無(wú)法生育:由于不明原因的不育癥:在目前檢查條件下無(wú)法明確病因,未接受治療的病人可采用試管嬰兒技術(shù)助孕。
還有家族遺傳疾病:任何一方夫妻都有遺傳性疾病或染色體,基因異常時(shí),可選擇第三代試管嬰兒激素,以防止后代發(fā)生遺傳病。
網(wǎng)友經(jīng)歷
中國(guó)江蘇網(wǎng)2016-03-02 08:54:57
中國(guó)江蘇網(wǎng)3月2日訊 為了給寶寶“最美好”的紀(jì)念,近日南京一名孕29周的準(zhǔn)媽媽,連續(xù)“奮戰(zhàn)”5小時(shí)拍攝大肚照,卻因?yàn)檫^(guò)度勞累,出現(xiàn)嘔心、心悸、流血等癥狀,在緊急送往醫(yī)院后,提前近兩個(gè)月早產(chǎn)下寶寶,孩子也被送進(jìn)了新生兒重癥監(jiān)護(hù)室救治。“很多準(zhǔn)爸爸準(zhǔn)媽媽希望通過(guò)相機(jī)記錄下美妙的一刻,留住珍貴的回憶,這沒(méi)有錯(cuò),但是要量力而行,把自己和寶寶折騰進(jìn)醫(yī)院就得不償失了”,南京市婦幼保健院產(chǎn)房范裕如主任提醒,作為特殊的群體,準(zhǔn)媽媽們做事要結(jié)合身體狀況,凡事要多替胎兒與自己考慮。
孕婦拍攝大肚子照講究多
與過(guò)去孕媽媽們擔(dān)心身材變形、皮膚變差不愿意出門相比,現(xiàn)在的準(zhǔn)媽媽們把大肚子看成一種自豪的美,喜歡到影樓拍攝大肚照,還有些準(zhǔn)媽媽為追求效果愛(ài)在圓鼓鼓的肚皮上進(jìn)行彩繪。范主任說(shuō),如果拍照時(shí)間過(guò)長(zhǎng),化妝過(guò)濃,強(qiáng)光照射,拍照后沒(méi)有合理安排休息,都會(huì)使孕婦疲勞,由此有可能引起身體不適的狀況發(fā)生,情況嚴(yán)重的話,就會(huì)誘發(fā)早產(chǎn)等嚴(yán)重后果。
范主任建議準(zhǔn)媽媽們拍照時(shí)間不宜過(guò)長(zhǎng),同時(shí)一定要注意休息,不要與他人共用化妝品,也不要化濃妝以防化妝品中含有的重金屬元素和一些化學(xué)成分對(duì)胎兒造成不利影響。此外,拍照時(shí)盡量選擇干凈的服裝,或者自備服裝。需特別提醒的是,拍照過(guò)程必須有人陪伴,以防出現(xiàn)突發(fā)情況。
上海辣媽千里趕聚會(huì)引發(fā)早產(chǎn)
無(wú)獨(dú)有偶,就在這位準(zhǔn)媽媽連續(xù)“奮戰(zhàn)”5小時(shí)拍攝大肚照引發(fā)早產(chǎn)的當(dāng)日,一位從上海奔赴南京參加同學(xué)聚會(huì)的辣媽同樣早產(chǎn)。寶寶同樣被送進(jìn)了新生兒重癥監(jiān)護(hù)室救治,而這位媽媽的孕周更小,只有27周。
溫馨提示
廣州市婦幼保健院是一家專業(yè)的婦女兒童醫(yī)院,也是廣州市的一家三級(jí)甲等醫(yī)院。該醫(yī)院代孕服務(wù)以其專業(yè)化、規(guī)范化和高效率著稱,擁有一支專業(yè)的代孕醫(yī)療團(tuán)隊(duì)和一流的醫(yī)療設(shè)備,為廣大客戶提供高品質(zhì)的代孕服務(wù)。
總之,廣州代懷孩子哪家公司好?以上這些權(quán)威助孕醫(yī)院都是不錯(cuò)的選擇,它們擁有一流的醫(yī)療設(shè)備和專業(yè)的醫(yī)療團(tuán)隊(duì),能夠?yàn)閺V大需要代孕的家庭提供高品質(zhì)的代孕服務(wù)。如果你有需要,可以選擇其中一家來(lái)咨詢。
tips
Tips:
無(wú)論是達(dá)菲林還是亮丙瑞林,大家都不能盲目使用,就拿達(dá)菲林來(lái)說(shuō),錯(cuò)誤的使用很容易影響其藥效,甚至出現(xiàn)某些不良反應(yīng),因此明確達(dá)菲林怎么注射是很如有必要的。當(dāng)然,使用亮丙瑞林也不例外,也需要在相關(guān)醫(yī)生的指導(dǎo)下注射。




















